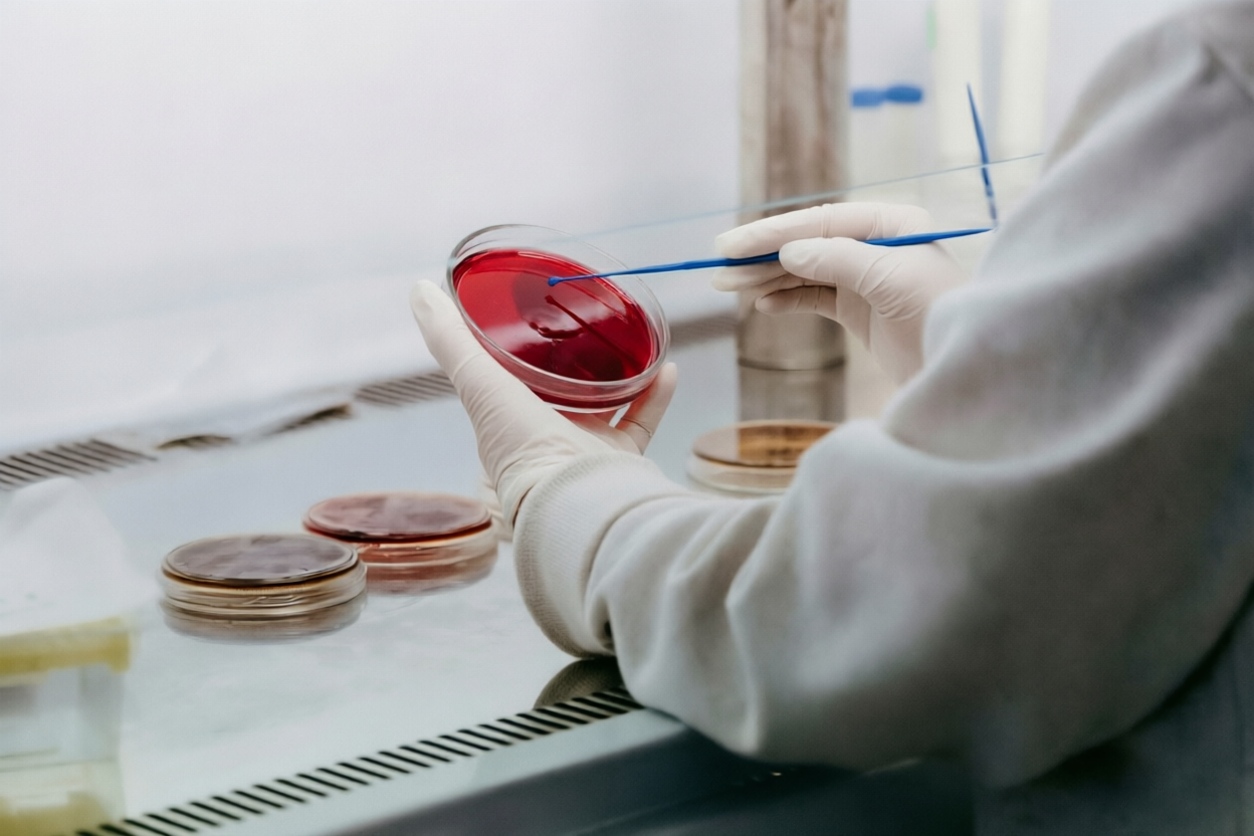

Welcome to the official our website
🏭 Asian Manufacturing Capabilities
Ice Cream
Moulding, extrusion, sandwich, stick & cup lines. MOQ as low as 1,000 cartons.
Supplements
Gummy depositors, high-speed tablet presses, liquid filling. GMP & NSF certified.
Beverages
Hot-fill, cold-fill, aseptic lines. Can, PET, glass, and flexible pouches.
Desserts & Snacks
Pudding cups, jelly sticks, baked goods, rice snacks — custom formulations.
⚙️ JW Trade · Custom Manufacturing Advantages
- ✅ Turnkey solution — From idea to finished product: formulation, packaging design, compliance, and logistics.
- ✅ Low MOQ flexibility — Start with small batches to test the market, scale up with demand.
- ✅ Regulatory support — We help with label claims, nutrition facts, and import requirements for your target market.
- ✅ Speed to market — Streamlined communication with Asian factories reduces lead times by 30-40%.
JW Trade · Custom Manufacturing | OEM/ODM tailored to your brand — from Asia to the world.
© JW Company — Your Product Development Partner
________________________________________________________________________________________________________________________________________________________________________________________________________________________________________________________________________________________________________________________________


Custom Manufacturing
From recipe to packaging, developed on demand. Fruit‑shaped ice cream customization, supplement format selection, matcha beverage concentration adjustment — powered by Asian manufacturing capabilities to build your differentiated product line.
Ice Cream Customization
Fruit-shaped, character-inspired, or seasonal designs — we develop unique frozen novelties. Work with our R&D team to create textures, coatings, and inclusions that stand out on shelf.
Supplement Format Selection
Choose from gummies, tablets, softgels, powders, or stick packs. We help you match the right delivery format to your functional ingredients and target audience.
Beverage Concentration Control
Matcha, fruit juices, functional drinks — we adjust sweetness, pH, viscosity, and active ingredient levels to meet your brand’s exact specification.
🧪 Our Custom Development Process




OEM/ODM · Brand‑Exclusive Flavor Development
 Concept & Brief
Concept & BriefFlavor profile, packaging, target price
 R&D Sampling
R&D SamplingLab samples → sensory evaluation → adjustments
 Commercialization
CommercializationPilot run, scale-up, packaging validation
 Production & Delivery
Production & DeliveryFull-scale manufacturing with quality hold points